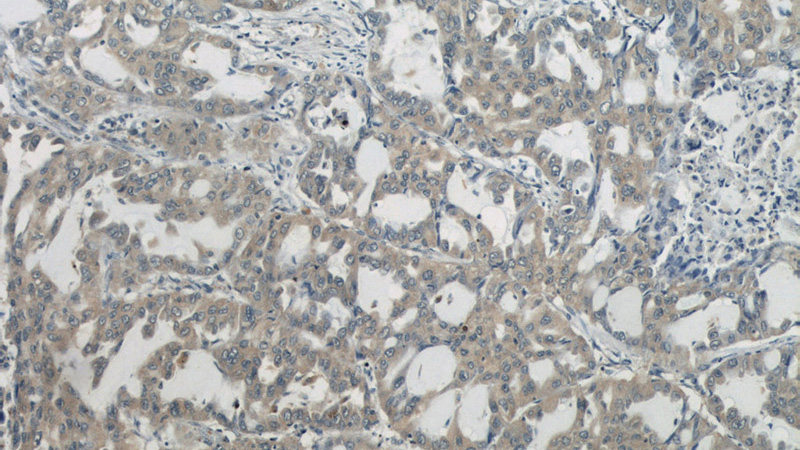
Immunohistochemistry of paraffin-embedded human lung cancer slide using Catalog No:107371(LAMR1,RPSA Antibody) at dilution of 1:50

-
Product Name
LAMR1,RPSA antibody
- Documents
-
Description
LAMR1,RPSA Mouse Monoclonal antibody. Positive IHC detected in human lung cancer tissue. Positive WB detected in Hela cells. Observed molecular weight by Western-blot: 40 kDa
-
Tested applications
ELISA, WB, IHC
-
Species reactivity
Human, Mouse; other species not tested.
-
Alternative names
37/67 kDa laminin receptor antibody; 37LRP antibody; 40S ribosomal protein SA antibody; 67 kDa laminin receptor antibody; 67LR antibody; LAMBR antibody; Laminin receptor antibody; Laminin receptor 1 antibody; LamR antibody; LAMR1 antibody; LBP/p40 antibody; LRP antibody; LRP/LR antibody; NEM/1CHD4 antibody; p40 antibody; ribosomal protein SA antibody; RPSA antibody
-
Isotype
Mouse IgG2b
-
Preparation
This antibody was obtained by immunization of LAMR1,RPSA recombinant protein (Accession Number: NM_002295). Purification method: Caprylic acid/ammonium sulfate precipitation.
-
Clonality
Monoclonal
-
Formulation
PBS with 0.1% sodium azide and 50% glycerol pH 7.3.
-
Storage instructions
Store at -20℃. DO NOT ALIQUOT
-
Applications
Recommended Dilution:
WB: 1:500-1:5000
IHC: 1:20-1:200
-
Validations

HeLa cells were subjected to SDS PAGE followed by western blot with Catalog No:107371(LAMR1,RPSA antibody) at dilution of 1:500
Immunohistochemistry of paraffin-embedded human lung cancer slide using Catalog No:107371(LAMR1,RPSA Antibody) at dilution of 1:50
-
Background
The ribosomal protein SA (RPSA), previously named 67 kD laminin receptor(67LR), 37 kD laminin receptor precursor (37LRP) and p40 ribosome-associated protein, is a multifunctional protein, that plays a role in a number of pathological processes, such as cancer and prion diseases. It is overexpressed in various cancer cell lines, and the the level of the laminin receptor transcript is higher in colon carcinoma tissue and lung cancer cell line than their normal counterparts. This antibody is a mouse monoclonal antibody raised against full length RPSA of human origin. It is specific to RPSA (LAMR1).
Related Products / Services
Please note: All products are "FOR RESEARCH USE ONLY AND ARE NOT INTENDED FOR DIAGNOSTIC OR THERAPEUTIC USE"
